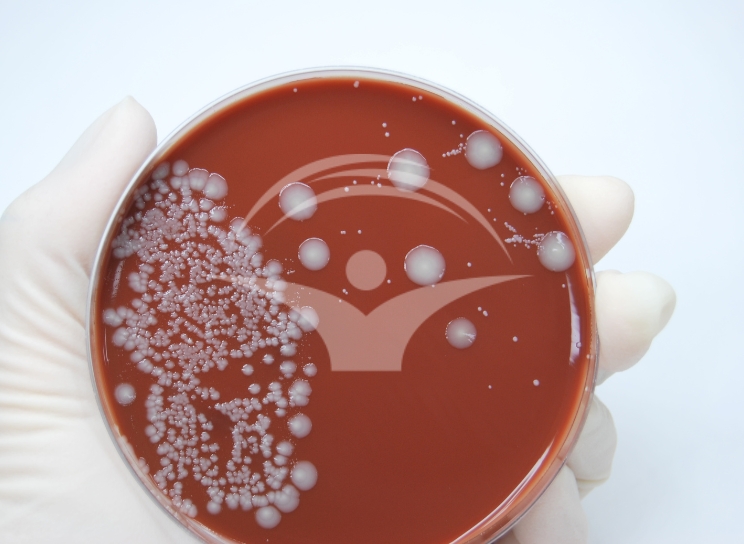

Cuprins
- Boli care se pot transmite prin consumul de alimente contaminate
- Patogenii transmisi frecvent prin alimente contaminate
- Infectii gastrointestinale simptome
- Cum reducem riscul de a contracta o infectie prin consumul de alimente contaminate?
Boli care se pot transmite prin consumul de alimente contaminate
Contaminarea alimentelor constituie o problema de sanatate publica majora. Consumul de alimente si apa contaminate poate determina aparitia unor manifestari clinice si afectiuni ce variaza de la diaree usoara si pana la probleme medicale severe. Printre bolile care se pot transmite prin ingerarea alimentelor contaminate sau a apei contaminate, se numara:
- Diareea calatorului
- Toxiinfectia alimentara
- Enterocolita (gastroenterita acuta) de diferite cauze – virala, mai rar bacteriana si parazitara
- Enteroviroza (gastroenterita virala sau „raceala la stomac ”) - infectiile intestinale comune cu Rotavirus, Norovirus etc
- Shigelloza (dizenteria bacilara)
- Salmoneloza
- Infectia enteropatogena cauzata de E. coli, E. coli patogen, toxigen
- Infectia enterohemoragica (E. coli enterohemoragic)
- Enterita (Campylobacter).
Patogenii transmisi frecvent prin alimente contaminate
Virusurile intestinale, bacteriile si parazitii cel mai des implicati in transmiterea infectiilor prin ingestia de apa si mancare contaminate sunt:
Virusii intestinali
- Astrovirus
- Norovirus
- Rotavirus
- Adenovirusuri enterici
- Enterovirusuri
Bacterii
- Escherichia coli
- Campylobacter jejuni
- Shigella spp.
- Salmonella spp
Alte bacterii identificate prin analize de laborator
- Aeromonas spp.
- Plesiomonas spp.
- Acrobacter, Bacteroides fragilis enterotoxigen, Larobacter sunt agenti patogeni nou recunoscuti ca fiind o cauza potentiala a diareei calatorului
Paraziti
- Giardia
- Entamoeba histolytica si Cryptosporidium (cauze mai putin frecvente ale diareei calatorului)
- Cyclospora (sezonier, in anumite zone - Guatemala, Haiti, Nepal, Peru)
- Dientamoeba fragilis (asociat ocazional cu diareea calatorului).
Infectii gastrointestinale simptome
Manifestarile clinice, debutul lor, severitatea si durata simptomelor in cazul infectiilor gastrointestinale depind de tipul de virus, bacterie sau parazit care determina infectia, dar si de starea generala de sanatate a persoanei infectate. Cel mai frecvent apar:
- Diareea apoasa
- Greata si varsaturile
- Durerile abdominale (crampe)
- Senzatia de arsura in abdomen
- Balonarea
- Febra
- Lipsa poftei de mancare
- Senzatia de slabiciune si oboseala.
Mai rar, pot sa apara si sange in scaun, deshidratare (cauzata in special de pierderea excesiva de lichide prin varsaturi si diaree; nou-nascutii si sugarii sunt mai predispusi la deshidratare), dureri articulare si eruptii cutanate. Afla mai multe despre dezechilibrele hidroelectrolitice
Simptomatologia specifica infectiilor gastrointestinale apare intre 6 si 72 de ore in cazul infectiilor de cauza virala si bacteriana, iar in cazul parazitilor, unde perioada de incubatie este mai lunga, pot aparea simptome dupa 1 – 2 saptamani de la ingestia alimentului contaminat.
Este necesar un consult medicat cat mai repede posibil in situatiile in care apar:
- Sange in scaun
- Semne de deshidratare (la copiii mici - ochi infundati in orbite, gura uscata, stare de letargie)
- Diaree care persista mai mult de 24 de ore
- Varsaturi severe
- Dureri abdominale severe
- Febra inalta, insotita sau nu de frisoane si transpiratii
- Confuzie
- Dificultati de respiratie
- Ritm cardiac accelerat.
Formular de programare
Cum reducem riscul de a contracta o infectie prin consumul de alimente contaminate?
- Evitam fructele si legumele care nu pot fi decojite, la fel si salatele proaspete, acestea pot fi contaminate cu bacterii, virusi sau paraziti din sol, din apa, ori printr-o manipulare defectuoasa (neigienica).
- Nu consumam produse nepasteurizate (lapte, iaurt si derivate, inghetata, branza etc) – prin pasteurizare sunt distruse bacteriile precum E. coli, Salmonella, Listeria, Campylobacter. Laptele nepasteurizat poate fi contaminat cu bacterii patogene transmise de la animale bolnave (mastite la bovine, ovine, caprine).
- Nu consumam carnea cruda sau insuficient gatita deoarece poate fi contaminata cu bacterii. Bacteriile pot fi distruse doar prin gatirea corespunzatoare.
- Consumate crude sau insuficient gatite, fructele de mare prezinta un risc si mai mare de contaminare. Fructele de mare si pestele (in special cel pescuit din recifurile tropicale) pot fi purtatoare de bacterii, virusi sau paraziti, spre exemplu Vibrio, norovirus ori parazitii din genul Anisakis.
- Acordam atentie sosurilor si produselor precum mustar, sos de tomate, dressing-uri. Lasate pentru mult timp la temperatura camerei (2 ore sau mai mult de 1 ora in cazul in care temperatura ambientala depaseste 32° C) pot deveni medii de cultura pentru bacterii.
- Atentie si la gheata din bauturile racoritoare, apa folosita la obtinerea cuburilor de gheata poate sa provina din surse nepotabile.
Afla mai multe despre cum sa evitam tulburarile digestive cand suntem in concediu
Alte masuri de preventie si reducere a riscului de infectie gastrointestinala prin consumul de alimente contaminate sunt reprezentate de:
- Igienizarea corespunzatoare a mainilor cu apa si sapun sau utilizarea unei solutii pe baza de alcool inainte de masa.
- Evitarea consumului de alimente in locatii care nu beneficiaza de spatii special amenajate pentru gatirea si pastrarea corespunzatoare a hranei sau variantele de „street-food”.
- Spalarea si/sau decojirea fructelor si legumelor inainte de a fi consumate in stare cruda.
- Consumarea doar a apei imbuteliate sau fiarta si racita. Evitati sursele de apa locala (fantani, izvoare, rauri sau apa de la chiuvete).
- De asemenea, nu inghititi apa in timpul inotului.
In cazul in care urmeaza sa calatoriti in zone tropicale, nu uitati de vaccinarea internationala. Calatoriile in anumite tari (zone tropicale, endemice) expun europenii la boli infectioase pentru care nu au imunitate sau nu au anticorpi. Pentru vacante fara griji, inainte de calatorie este recomandat consultul la un medic specialist (Boli infectioase, Epidemiologie, Medicina de Calatorie).
Referinte:
- Digestive disorders, Frances Harcourt-Brown, National Library of Medicine
- E. coli (Escherichia coli), Centers for Disease Control and Prevention CDC)
- Food Poisoning and Staphylococcus aureus Enterotoxins
- Gastroenteritis Viruses: An Overview, Roger I. Glass, Joseph Bresee, Baoming Jiang, Jon Gentsch, Tamie
- General advice for the international traveler, Elaine C. Jong, Russell McMullen
- Salmonella: A Postmodern Pathogen, Robert V. Tauxe